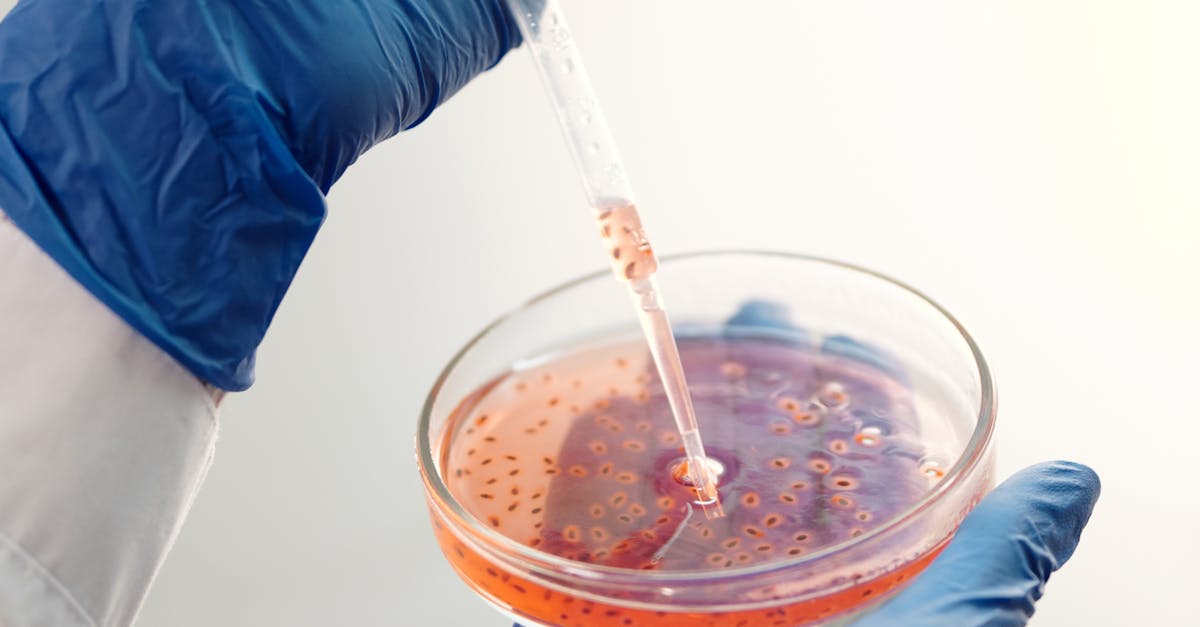

8 Gene Editing Applications Moving from Lab to Clinical Use
The revolutionary field of gene editing has reached a pivotal moment in medical history, transitioning from experimental laboratory techniques to tangible clinical applications that promise to transform patient care. CRISPR-Cas9, along with other advanced gene editing technologies like base editing and prime editing, has evolved from a scientific curiosity into a powerful therapeutic tool capable of addressing previously incurable genetic disorders. This remarkable journey from bench to bedside represents decades of meticulous research, technological refinement, and regulatory navigation. As we stand at the threshold of a new era in precision medicine, eight groundbreaking gene editing applications are leading the charge from laboratory settings into clinical trials and approved treatments. These applications span a diverse range of medical conditions, from inherited blood disorders and cancer to infectious diseases and organ transplantation challenges. Each represents not only a scientific breakthrough but also hope for millions of patients worldwide who have been waiting for effective treatments. The convergence of improved editing precision, enhanced delivery methods, and better understanding of genetic mechanisms has created an unprecedented opportunity to rewrite the future of medicine, offering the potential to cure diseases at their genetic source rather than merely managing symptoms.
1. Sickle Cell Disease Treatment - Rewriting Blood Cell Genetics

Sickle cell disease represents one of the most successful early applications of therapeutic gene editing, demonstrating the technology's potential to cure inherited blood disorders. This devastating condition, caused by a single nucleotide mutation in the beta-globin gene, affects millions worldwide and has historically been managed through supportive care and bone marrow transplantation. Gene editing approaches for sickle cell disease primarily focus on two strategies: directly correcting the disease-causing mutation or reactivating fetal hemoglobin production to compensate for the defective adult hemoglobin. Clinical trials using CRISPR-Cas9 to edit patients' own hematopoietic stem cells have shown remarkable success, with treated patients experiencing dramatic reductions in pain crises and transfusion requirements. The treatment involves harvesting the patient's bone marrow cells, editing them ex vivo to either correct the mutation or enhance fetal hemoglobin production, and then reinfusing the modified cells back into the patient. Early results from companies like Vertex Pharmaceuticals and CRISPR Therapeutics have demonstrated sustained clinical benefits lasting over two years, with some patients achieving transfusion independence. This success has paved the way for regulatory approvals and represents a paradigm shift from managing sickle cell disease to potentially curing it, offering hope to patients who previously faced a lifetime of complications and reduced quality of life.
2. Beta-Thalassemia Correction - Restoring Hemoglobin Production

Beta-thalassemia, another inherited blood disorder characterized by reduced or absent beta-globin chain production, has emerged as a prime target for gene editing therapeutics, building upon the success seen in sickle cell disease treatment. This condition affects hundreds of thousands of people globally, particularly those of Mediterranean, Middle Eastern, and Asian descent, causing severe anemia, organ damage, and requiring lifelong blood transfusions. The gene editing approach for beta-thalassemia involves similar techniques to those used in sickle cell disease, focusing on editing the patient's hematopoietic stem cells to restore normal hemoglobin production. Clinical trials have demonstrated that CRISPR-edited cells can successfully engraft in patients and produce sufficient levels of functional hemoglobin to reduce or eliminate transfusion dependence. The treatment protocol involves mobilizing and collecting the patient's stem cells, performing precise gene editing to correct the underlying genetic defect, and then transplanting the corrected cells back into the patient after conditioning chemotherapy. Results from ongoing trials show that patients treated with gene-edited cells have achieved transfusion independence for extended periods, with some maintaining stable hemoglobin levels for over three years post-treatment. The success in beta-thalassemia has validated the broader potential of gene editing for treating inherited blood disorders and has accelerated research into similar approaches for other hemoglobinopathies, establishing a new standard of care that could transform the lives of patients worldwide.
3. CAR-T Cell Enhancement - Supercharging Cancer Immunotherapy

The integration of gene editing with CAR-T cell therapy represents a revolutionary advancement in cancer treatment, combining the precision of genetic modification with the power of engineered immune cells to create more effective and safer cancer-fighting tools. Traditional CAR-T therapy involves extracting a patient's T cells, genetically modifying them to recognize and attack cancer cells, and reinfusing them back into the patient. However, gene editing technologies like CRISPR-Cas9 have enabled researchers to make additional modifications that enhance the therapy's effectiveness and reduce side effects. These improvements include editing out genes that cause T cell exhaustion, inserting genes that help T cells survive longer in the hostile tumor environment, and removing immune checkpoint proteins that cancer cells exploit to evade detection. Clinical trials are exploring gene-edited CAR-T cells for various blood cancers and solid tumors, with early results showing improved persistence and anti-tumor activity compared to conventional CAR-T therapies. Additionally, gene editing allows for the creation of "universal" CAR-T cells from healthy donors, potentially making this therapy more accessible and cost-effective by eliminating the need for patient-specific manufacturing. Companies like Allogene Therapeutics and Cellectis are advancing these off-the-shelf approaches through clinical development, with the goal of creating standardized, immediately available cancer treatments that could benefit patients who cannot wait for personalized cell manufacturing or whose own T cells are too compromised by previous treatments.
4. Leber Congenital Amaurosis - Restoring Vision Through Gene Correction

Leber Congenital Amaurosis (LCA), a group of inherited retinal dystrophies that cause severe vision loss or blindness from birth, has become a compelling target for in vivo gene editing applications, representing the frontier of treating genetic blindness directly within the eye. This condition, affecting approximately 1 in 80,000 newborns, is caused by mutations in various genes essential for photoreceptor function, with LCA10 (caused by CEP290 mutations) being particularly amenable to gene editing approaches. Unlike systemic gene editing applications, treating LCA involves direct injection of gene editing components into the eye, taking advantage of the organ's immune-privileged status and accessibility. The EDIT-101 trial by Editas Medicine represents the first in vivo CRISPR trial, using a lipid nanoparticle delivery system to transport gene editing components directly to photoreceptor cells in the retina. The treatment aims to correct the specific mutation in the CEP290 gene that causes LCA10, potentially restoring the production of functional protein necessary for vision. Early clinical results have shown the treatment to be well-tolerated, with some patients experiencing improvements in light sensitivity and visual function. This approach is particularly significant because it demonstrates the feasibility of performing gene editing directly in human tissues rather than in extracted cells, opening possibilities for treating other organs and conditions that cannot be addressed through ex vivo editing approaches. The success of ocular gene editing could pave the way for treating other inherited eye diseases and establish protocols for in vivo editing in other organs.
5. Duchenne Muscular Dystrophy - Restoring Muscle Function
Duchenne Muscular Dystrophy (DMD), a devastating X-linked genetic disorder affecting approximately 1 in 3,500 male births, represents one of the most challenging targets for gene editing due to the large size of the dystrophin gene and the systemic nature of muscle involvement throughout the body. This progressive muscle-wasting disease is caused by mutations in the dystrophin gene that result in absent or non-functional dystrophin protein, leading to muscle fiber damage, weakness, and ultimately respiratory and cardiac failure. Gene editing approaches for DMD focus on restoring dystrophin expression through various strategies, including exon skipping to restore the reading frame, direct correction of point mutations, or insertion of functional mini-dystrophin genes. The complexity of treating DMD lies in the need to deliver gene editing tools to muscles throughout the body, including the heart and diaphragm, which are critical for survival. Researchers are exploring multiple delivery methods, including adeno-associated virus (AAV) vectors and lipid nanoparticles, to achieve widespread muscle targeting. Clinical trials led by companies like Solid Biosciences and Sarepta Therapeutics are investigating systemic delivery of gene editing components, with early results showing promise in restoring dystrophin expression in muscle biopsies. The challenge extends beyond just correcting the genetic defect to ensuring that the restored dystrophin protein is produced at sufficient levels and in the right locations to meaningfully improve muscle function. Success in DMD gene editing would not only provide hope for affected patients and families but also establish important precedents for treating other systemic genetic disorders that require body-wide gene correction.
6. HIV Treatment and Prevention - Editing for Viral Resistance

The application of gene editing to HIV treatment and prevention represents a groundbreaking approach to combating one of the world's most persistent viral pandemics, offering the potential for functional cures rather than lifelong antiretroviral therapy. HIV's ability to integrate into the host genome and establish latent reservoirs has made it notoriously difficult to eliminate from infected individuals, but gene editing technologies are providing new strategies to either remove the virus or render cells resistant to infection. The most promising approach involves editing the CCR5 gene in T cells, creating cells that are naturally resistant to HIV infection, similar to the rare individuals with natural CCR5 mutations who are protected from HIV. Clinical trials are exploring both therapeutic applications, where T cells from HIV-positive patients are edited and reinfused to create a resistant immune system, and preventive applications for high-risk individuals. Additionally, researchers are investigating direct targeting of HIV DNA integrated into the host genome using CRISPR-Cas9 to excise viral sequences from infected cells. Companies like American Gene Technologies and Excision BioTherapeutics are advancing these approaches through clinical development, with early results showing successful gene editing and some evidence of viral load reduction. The complexity of HIV treatment lies in the virus's genetic diversity and its ability to hide in various tissue reservoirs throughout the body, requiring sophisticated delivery methods and comprehensive targeting strategies. Beyond individual treatment, gene editing approaches to HIV could potentially contribute to population-level prevention strategies, particularly in regions with high HIV prevalence, representing a paradigm shift from treatment to prevention and potentially contributing to the eventual elimination of HIV as a public health threat.
7. Primary Immunodeficiencies - Rebuilding Immune Systems

Primary immunodeficiencies, a group of inherited disorders affecting the development and function of the immune system, have emerged as ideal targets for gene editing therapeutics due to their single-gene causes and the life-threatening nature of these conditions. Severe Combined Immunodeficiency (SCID), often called "bubble boy disease," exemplifies the potential of gene editing to restore immune function in patients who would otherwise require lifelong isolation or risky bone marrow transplantation. These disorders affect various components of the immune system, including T cells, B cells, and natural killer cells, leaving patients vulnerable to severe infections and malignancies from birth. Gene editing approaches for primary immunodeficiencies involve correcting the specific genetic defects in hematopoietic stem cells, which can then differentiate into functional immune cells throughout the patient's lifetime. Clinical trials are exploring CRISPR-based corrections for various forms of SCID, including ADA-SCID, X-linked SCID, and Artemis-deficient SCID, each requiring precise editing strategies tailored to the specific genetic defect. The advantage of gene editing over traditional gene therapy approaches lies in the precision of correction, avoiding the risk of insertional mutagenesis that has been associated with viral vector-based treatments. Early clinical results have shown successful gene editing in patient cells and evidence of immune system reconstitution, with treated patients developing functional T cells and improved responses to vaccines and infections. Companies like Graphite Bio and Beam Therapeutics are advancing these applications, with the goal of providing curative treatments for children who currently have limited therapeutic options. The success in treating primary immunodeficiencies not only offers hope for affected families but also validates the broader potential of gene editing for treating inherited immune disorders and establishes important safety and efficacy precedents for pediatric gene editing applications.
8. Hereditary Transthyretin Amyloidosis - Silencing Disease-Causing Genes

Hereditary Transthyretin Amyloidosis (hATTR) represents a unique application of gene editing technology, utilizing in vivo base editing to permanently silence the production of disease-causing transthyretin protein in the liver, offering a potential cure for this progressive and fatal disorder. This rare genetic condition is caused by mutations in the TTR gene that lead to the production of misfolded transthyretin protein, which accumulates as amyloid deposits in various organs, particularly affecting the nervous system and heart. Traditional treatments have focused on stabilizing the abnormal protein or reducing its production through RNA interference, but gene editing offers the possibility of permanently eliminating the source of the problem. The NTLA-2001 treatment by Intellia Therapeutics uses lipid nanoparticles to deliver CRISPR-Cas9 components directly to liver cells, where they create precise cuts in the TTR gene to permanently reduce transthyretin production. Clinical trial results have demonstrated sustained reductions in disease-causing protein levels of up to 87% after a single treatment, with effects lasting for months and showing potential for permanent correction. This approach is particularly significant because it represents one of the first successful applications of in vivo gene editing for a systemic genetic disorder, proving that gene editing can be safely and effectively delivered to internal organs. The treatment's success has implications beyond hATTR, potentially paving the way for similar approaches to other liver-produced disease proteins and establishing important precedents for in vivo gene editing safety and efficacy. The ability to achieve such dramatic and sustained effects with a single treatment represents a paradigm shift from chronic disease management to potential cures, offering hope for patients with this devastating condition and their families.
9. Future Horizons - Expanding Applications and Overcoming Challenges

The transition of gene editing from laboratory research to clinical application represents just the beginning of a therapeutic revolution that promises to expand into virtually every area of medicine, with emerging applications targeting neurological disorders, metabolic diseases, and even aging-related conditions. As the eight current applications demonstrate clinical success and safety, researchers are already developing next-generation editing tools with improved precision, reduced off-target effects, and enhanced delivery capabilities. Prime editing and base editing technologies are enabling more subtle genetic modifications, while advances in delivery systems are making it possible to target previously inaccessible tissues and organs. The future landscape includes potential treatments for Huntington's disease, Alzheimer's disease, and various forms of inherited blindness, as well as applications in regenerative medicine and organ transplantation. However, significant challenges remain, including the need for more efficient delivery methods, better understanding of long-term safety profiles, and addressing the high costs associated with personalized genetic medicines. Regulatory frameworks are evolving to accommodate these novel therapies, with agencies like the FDA developing specialized pathways for gene editing treatments while maintaining rigorous safety standards. The democratization of gene editing technology and the development of more cost-effective manufacturing processes will be crucial for ensuring global access to these life-changing treatments. As we look toward the future, the integration of artificial intelligence with gene editing design, the development of in vivo editing capabilities for more organs, and the potential for germline editing applications (where ethically appropriate) suggest that we are only beginning to realize the full potential of genetic medicine. The success of current clinical applications provides a foundation for this expanding field, promising a future where genetic diseases are not just managed but cured, fundamentally changing the practice of medicine and offering hope to millions of patients worldwide.







